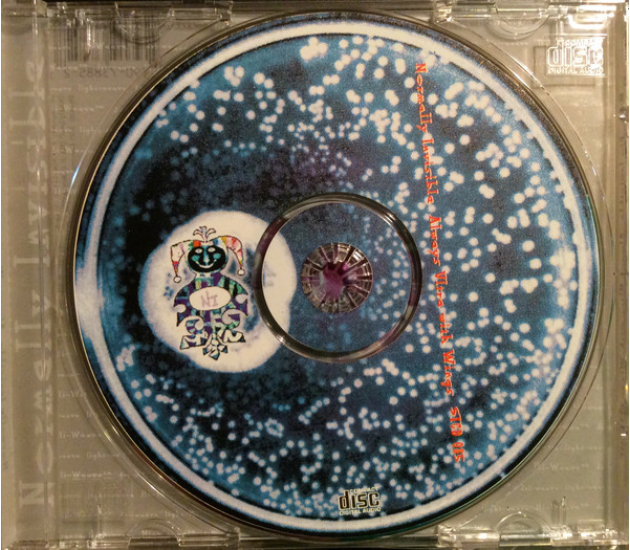
Normally Invisible – Always Ultra With Wings (CD, 1995)

Normally Invisible – Always Ultra With Wings (CD, 1995)
€ 14,95
-
+
In winkelmandje
Op voorraad
Product omschrijving
Tracklist:
01 What Remains...
02 Tiny Chant
03 Keep Calling
04 Psychotronics
05 Clockwork
06 Sorry To Miss Them
07 11Hz And Other Frequencies
08 Moebius
09 Bloody Cellar
10 Colt .45
11 Open Mind
Normally Invisible - Always Ultra With Wings
Staalplaat • Netherlands • 1995 • CD • Cat#: STCD 085 • EAN: 753907388527
Barcodes & Other Identifiers:
Barcode: 7 5390-73885-2 7
Matrix / Runout: DADC AUSTRIA STCD085 13 A1
Mastering SID Code: IFPI L553
Mould SID Code: IFPI 94B3
01 What Remains...
02 Tiny Chant
03 Keep Calling
04 Psychotronics
05 Clockwork
06 Sorry To Miss Them
07 11Hz And Other Frequencies
08 Moebius
09 Bloody Cellar
10 Colt .45
11 Open Mind
Normally Invisible - Always Ultra With Wings
Staalplaat • Netherlands • 1995 • CD • Cat#: STCD 085 • EAN: 753907388527
Barcodes & Other Identifiers:
Barcode: 7 5390-73885-2 7
Matrix / Runout: DADC AUSTRIA STCD085 13 A1
Mastering SID Code: IFPI L553
Mould SID Code: IFPI 94B3
Eigenschappen
Artikelnummer
ZH-6
EAN
753907388527
Artiest
Normally Invisible
Genre
Electronic
Media
CD
Jaar
1995
Label
Staalplaat
Catalogusnummer
STCD 085
Land van uitgave
Netherlands
Matrix / Runout
DADC AUSTRIA STCD085 13 A1
Opmerking
Geen originele hoes en boekje
Staat hoes
Sleeve transparant (Losse CD)
Staat media
VG+ (Very good plus)
Staat
Tweedehands